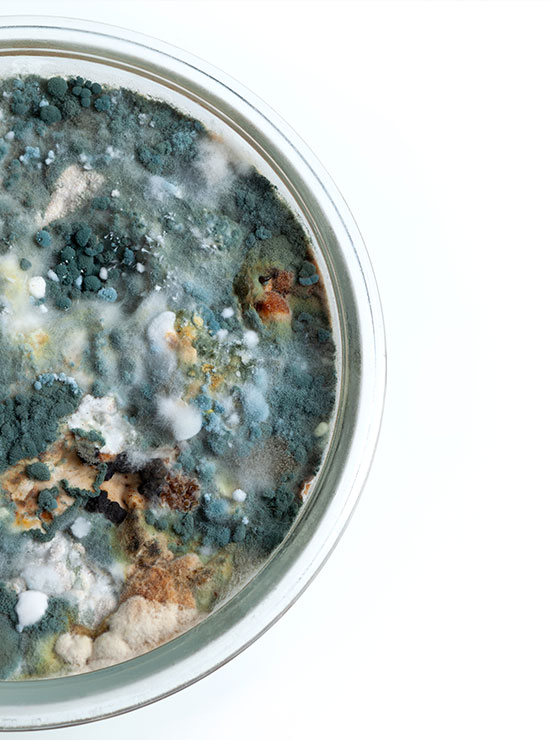
wat is zwarte schimmel

Last van schimmel in uw woning? Doe er dan zo snel mogelijk iets aan. Zwarte schimmel kan namelijk schade berokkenen aan uw woning en aan uw gezondheid. Zorg daarbij dat u niet enkel de schimmel verwijdert, maar ook de oorzaak van de schimmel behandelt. Alleen dan blijft de schimmel definitief weg. Hieronder leest u alvast wat de mogelijke gevolgen van zwarte schimmel zijn en hoe deze te behandelen.
Wat is zwarte schimmel?
We komen met heel wat schimmels in aanraking. De meest voorkomende schimmel in huis is de zwarte schimmel. Deze is te herkennen aan kleine zwarte stipjes die na verloop van tijd uitgroeien tot grote zwarte vlekken. Zwarte schimmel bevindt zich vooral in vochtige ruimtes van uw woning, zoals keuken, badkamer of wasruimte.
Hoe ontstaat zwarte schimmel?
Een schimmel bestaat uit minuscule kleine schimmelsporen die via deuren en ramen het huis kunnen binnen komen. Ze zijn niet zichtbaar met het blote oog. De sporen hechten zich op muren, plafonds en gordijnen. In een droge omgeving, kunnen ze zich niet ontwikkelen. Een vochtig oppervlak is een ideale voedingsbodem voor schimmels. Dat kan ontstaan door een vochtprobleem of door een tekort aan ventilatie.
Als een ruimte lange tijd aan vocht wordt blootgesteld zonder dat er frisse lucht wordt aangevoerd, zal de vochtige lucht zich hechten aan diverse oppervlakten zoals de muur. Zwarte schimmels hechten zich graag aan een vochtige plek en vermenigvuldigen zich enorm snel. Er ontstaan donkere vlekken die steeds groter worden. Dankzij schimmelsporen zal de schimmel zich ook naar andere ruimtes uitbreiden. Als het ook daar vochtig is, zullen de sporen zich ook daar erg vlot hechten.

Hoe gevaarlijk is zwarte schimmel voor de gezondheid?
Zwarte schimmels kunnen gevaarlijk zijn voor uw gezondheid. Zwarte schimmel kunnen mycotoxinen in huis brengen, wat giftige stoffen zijn. Wanneer u hier langdurig aan blootgesteld wordt en deze regelmatig inademt, kunnen er gezondheidsklachten ontstaan. Zwarte schimmel tast voornamelijk de luchtwegen aan. Zo kan u in eerste instantie beginnen hoesten of niezen. Gaandeweg kunnen deze klachten verergeren en zelfs chronisch worden. Denk aan bronchitis, astma of allergieën. In heel uitzonderlijke gevallen kunnen klachten ten gevolge van schimmel dodelijk zijn. Zeker voor mensen met een verzwakt immuunsysteem of een chronische aandoening, kan zwarte schimmel gevaarlijk zijn. Het is dus erg belangrijk om zwarte schimmel en het vochtprobleem eronder tijdig aan te pakken.
Hoe herkent u zwarte schimmel?
Zwarte schimmel is te herkennen aan de zwarte stipjes of donkere vlekken op muur, plafond of een ander oppervlak. De schimmelsporen waaruit de schimmel ontstaat, zijn niet waarneembaar met het blote oog. De zwarte stippen, en gaandeweg vlekken, ziet u wel waardoor u snel in actie kan schieten. Zwarte schimmel heeft ook een doffe geur omdat er in schimmels vaak bacteriën zitten. Deze geur kan in uw meubelen trekken. Als dit te lang duurt, zal deze geur niet meer weg gaan, zelfs niet als de zwarte schimmel werd behandeld.
Manieren om zwarte schimmel te verwijderen
U kan ervoor kiezen om de schimmel zelf te verwijderen of een vakman in te schakelen. Wanneer u te kampen heeft met grotere schimmelvlekken en zeker wanneer u zelf een longaandoening heeft, is een specialist aan te raden.
Zelf verwijderen
Als het aangetaste oppervlakte niet te groot of talrijk is, kan u zelf de schimmel proberen te verwijderen.
Gebruik hiervoor schoonmaakazijn in combinatie met soda. Een mengsel van water met chloor werkt ook goed. In de meeste supermarkten kan u ook speciale schimmeldodende en -werende middelen verkrijgen. Wees er wel voorzichtig mee. Deze middelen zijn bijtend. Gebruik handschoenen om huidirritatie te voorkomen. Ook een mondmasker is aan te raden.
Bij het verwijderen van schimmels komt er in één keer een enorme hoeveelheid aan schimmelsporen vrij en deze kunnen een schadelijk effect hebben op de luchtwegen als u ze inademt. Verwijder de schimmel nooit droog. Dan kan u immers schimmelsporen inademen en kunnen ze zich verder verspreiden.
Laat schimmel verwijderen door een professional
Begint u liever niet zelf aan het verwijderen van schimmels?
Is de schimmel te hardnekkig of gaat het om grote plekken? Of heeft een luchtwegaandoening? Dan is het aan te raden om een professional in te schakelen. Uw gezondheid wordt dan zeker niet geschaad en u hoeft zich geen zorgen maken over bijtende middelen of schimmelsporen. Ook kan de specialist een correcte diagnose stellen over het onderliggend probleem zodat er een definitieve oplossing kan komen. Is uw woning ouder dan tien jaar? Dan hebt u recht op het verlaagde btw-tarief van 6%.
Zoek het onderliggend probleem
Indien de schimmel is verwijderd, is het erg belangrijk om het onderliggende vochtprobleem te behandelen. Als u enkel de zwarte schimmel verwijdert zonder het onderliggend probleem op te lossen, zal de schimmel steeds terug keren. Het is dus geen oplossing op lange termijn. Een professional kan een deskundige diagnose stellen en advies geven over de meest effectieve aanpak.
Waar in huis groeit zwarte schimmel?
Zolang er voldoende vocht is, kan schimmel overal groeien. Meestal worden ze ontdekt in vochtige ruimtes zoals de badkamer omdat ze daar het best kunnen groeien. Evengoed kan schimmel op heel andere plaatsen opduiken. Er zijn verschillende oorzaken die aan de basis liggen.
Onderaan de muur begane grond
Wanneer de schimmel zich grotendeels onderaan de muur bevindt en er geen waterleidingen lopen, gaat het wellicht om opstijgend vocht. Dat is grondwater dat in de muren omhoog trekt. Oorzaak kunnen slechte funderingen, slechte waterkering of het ontbreken van een waterkering zijn. De meest efficiënte manier om af te geraken van opstijgend vocht, is het injecteren van de muren. Een vakman boort gaten in de muur waarlangs hij vochtwerend middel inspuit. Het product trekt in het metselwerk en vormt een waterkerende laag.
Schimmel op de hele muur
Wanneer de schimmel niet (enkel) onderaan de muur voorkomt, kan het gaan om doorslaand vocht. Hierbij dringt regenmater in een buitenmuur die poreus is om zich nadien verder te verspreiden. Verven met vochtwerende verf of het laten impregneren van de buitenmuur, kunnen hierbij helpen. Een meer drastische oplossing is kiezen voor een nieuwe gevelbekleding. Het kan ook zijn dat het om condensatievocht gaat waarbij warme lucht neerkomt op koude oppervlakken. De meest geschikte oplossing hangt af van het specifieke probleem. Laat door een vakman een diagnose stellen.



Achter kasten, in een kamerhoek of koude plekken
Wanneer schimmels zich achter kasten, in kamerhoeken of op andere koude plekken tevoorschijn komen, hebt u vermoedelijk te maken met condensatievocht. Hierbij zet warme lucht zich af op koude oppervlakken om vervolgens te condenseren. Een efficiënt ventilatiesysteem dat lucht tijdig afvoert en zuivert, kan dit voorkomen. Een verhoogde luchtvochtigheid kan ook ontstaan door bepaalde vochtproblemen zoals opstijgend vocht. Als dat het geval is, schakelt u best een vakman in om te kijken wat de beste remedie is.
Op plafonds, bij leidingen, onder het dak
Wanneer schimmels op het plafond, aan het dak of ter hoogte van een waterleiding verschijnen, gaat het wellicht om een lek. Als tegelijkertijd ook nog eens uw waterverbruik en energiekosten stijgen, kan u hier wel zeker van zijn. Lekkages komen niet zo vaak voor, maar kunnen wel de oorzaak vormen van zwarte schimmel. De oplossing is uiteraard het lek (laten) dichten. Een lekdetectiebedrijf kan uitzoeken waar het lek zich precies bevindt wanneer dit niet zichtbaar zou zijn.
Badkamer
De badkamer is de ideale plek voor schimmels. Schimmelsporen zullen zich in een vochtige omgeving sneller hechten en vermenigvuldigen. Bovendien groeien ze het best tussen de 17 en 25 graden. Ook lekkages of opstijgend vocht kunnen aan de basis liggen van schimmel in de badkamer.
Kelder
Een kelder kan te maken hebben met opstijgend vocht aangezien deze ruimte in rechtstreeks contact staat met de aarde. Als het grondwater niet vlot weg kan, komt het naar boven en worden vloer en muren vochtig. Een schimmel kan zich dan makkelijk nestelen.
Wat kost het om zwarte schimmel te verwijderen?
Gemiddeld betaalt u zo’n €25,- à €35,-per vierkante meter om zwarte schimmel door een professional te laten verwijderen. Deze prijs bevat zowel het materiaal als de werkuren.
Wanneer u opstijgend vocht laat behandelen door een muurinjectie, moet u rekenen op zo’n €100,- per lopende meter.
Het installeren van een aangepast ventilatiesysteem om condensatievocht te bestrijden, kan vanaf €500,- tot wel €8.000,- kosten.
Het laten impregneren van muren kost gemiddeld €8,- à €12,- per vierkante meter.
Vochtwerend verven kost u zo’n €20,- à €40,- per vierkante meter en een nieuwe gevelbekleding start aan €40,- per vierkante meter.
Voor lekdetectie betaalt u tot slot al snel €300,- tot €500,-.
Hoe voorkomt u zwarte schimmel in uw woning?
Ventileren is het sleutelwoord om zwarte schimmel te vermijden. Schimmels houden van vocht. Een goede ventilatie voorkomt de opbouw van schimmelsporen aangezien de lucht niet vochtig blijft. Zorg dus voor een voortdurende aanstroom van verse lucht via het open zetten van een raam, ventilatieroosters of mechanische ventilatie. Zeker in vochtige ruimtes zoals de badkamer. Zorg er ook voor dat de temperatuur in uw woning niet te hoog is in vochtige ruimtes. De combinatie van vocht en warmte is ideaal voor schimmels.
Daarnaast kunnen ook vochtproblemen zorgen voor schimmels, denk aan lekkages of doorslaand vocht in de muur. Laat vochtproblemen als deze zo snel mogelijk verhelpen zodat schimmels zich niet kunnen hechten en vermenigvuldigen. Een vochtprobleem kan een lokaal iets lijken, maar schimmels breiden zich snel uit. Tot slot is het ook belangrijk om voor een goede hygiëne te zorgen zodat schimmels geen voedingsbodem krijgen. Ze nestelen zich immers makkelijk op een vuile ondergrond.
Lees meer over schimmelsaneringen in woningen. [uitgaande link naar dossier van WTCB]
Snel van zwarte schimmel af!
Last van zwarte schimmel die dringend moet verwijderd worden? Vraag dan eerst meerdere offertes aan. Zo bent u zeker van de beste prijs. Hier kan u alvast vrijblijvend offertes opvragen.
